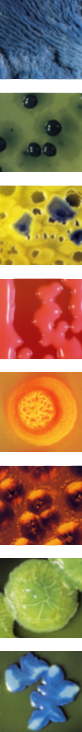

(mikrobiologische Therapie)
Auf allen menschlichen Schleimhäuten leben verschiedenste Bakterien, auf die wir dringend angewiesen sind, da sie u.a. ein integraler Bestandteil unseres Abwehrsystems sind. Es handelt sich dabei um ca. 500 verschiedene Bakterienarten, wobei allein die Anzahl der Darmbakterien auf 1014 (100.000.000.000.000) geschätzt wird, also mehr Einzeller als der menschliche Körper insgesamt an Zellen aufweist.
Auf allen menschlichen Schleimhäuten leben verschiedenste Bakterien, auf die wir dringend angewiesen sind, da sie u.a. ein integraler Bestandteil unseres Abwehrsystems sind. Es handelt sich dabei um ca. 500 verschiedene Bakterienarten, wobei allein die Anzahl der Darmbakterien auf 1014 (100.000.000.000.000) geschätzt wird, also mehr Einzeller als der menschliche Körper insgesamt an Zellen aufweist.
Da von diesem Zusammenleben sowohl der Mensch als auch die Bakterien profitieren, spricht man hier von einer Symbiose, da beide aufeinander angewiesen sind.
Kommt es durch ungesunde Ernährung und Lebensweise, durch Medikamente (insbesondere Antibiotika), Infektionen, Chemikalien und andere Umwelteinflüsse zu einer Störung diese empfindlichen Gleichgewichts (Dysbiose), bildet dieses die Grundlage für die Entstehung folgenreicher, meist chronischer Erkrankungen.
Die Symbioselenkung zielt als ganzheitliche Ursachentherapie darauf ab, durch Verabreichung von bakterienhaltigen Medikamenten diese Entgleisung gezielt zu beheben, das empfindliche Gleichgewicht der Bakterienflora wieder herzustellen, um so den entstandenen Folgeerkrankungen die Basis zu entziehen und eine dauerhafte Heilung zu ermöglichen.
Hierzu werden nach entsprechender mikrobiologischer Diagnostik (Schleimhautabstrich, Sputum- oder Stuhluntersuchung im Speziallabor) nach einem gestaffelten Anwendungsschema aufeinander abgestimmte Medikamente als Kur eingesetzt und häufig mit einer gleichzeitigen Ernährungsvorschrift kombiniert.
Symbioselenkung ist sinnvoll einzusetzen bei:
- Allergischen Erkrankungen:
Asthma bronchiale, Asthmoide Bronchitis, Chronisches Ekzem, Heuschnupfen, Lebensmittelunverträglichkeiten Neurodermitis
- Wiederkehrenden Infekten:
Bronchitis, Harnwegsinfekte, Kehlkopfentzündungen, Mittelohrentzündungen, Nasennebenhöhlenentzündungen, Schnupfen
- Erkrankungen des rheumatischen Formenkreises:
Weichteilrheuma, Fibromyalgie, Polyarthritis
- Krebserkrankungen:
als Zusatzbehandlung zur Immunstimulation
- Erkrankungen des Magen-Darm-Traktes:
Antibiotika-Folgeschäden, Colitis ulcerosa, Darmpilzerkrankung, Divertikulitis, Divertikulose, chron. Magenschleimhautentzündung, Magen-geschwür, Morbus Crohn, Refluxkrankheit, Zwölffingerdarmgeschwür
- Chron. Kopfschmerzsyndromen
Die Symbioselenkung ist ausgesprochen nebenwirkungsarm. Sie kann daher auch bei Kindern problemlos eingesetzt werden.
zurück
|